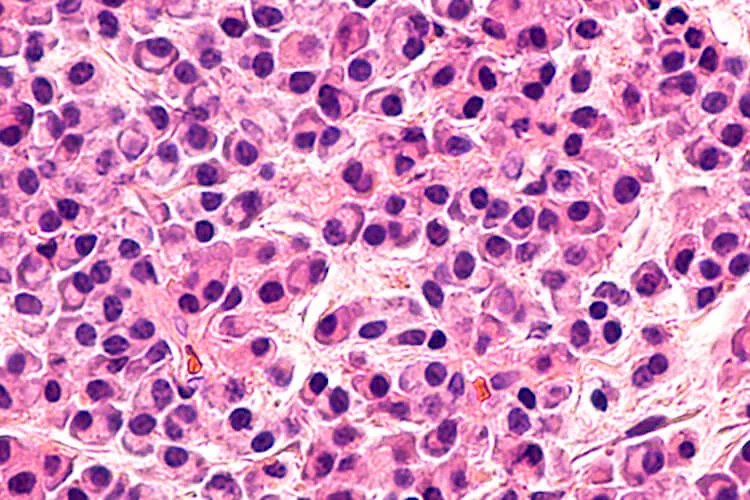
Ilustrační obrázek

Reportáže a rozhovory z odborných kongresů
V Bostonu byla na 17. mezinárodním myelomovém workshopu (IMW) v září 2019 prezentována také analýza registru švédské myelomové skupiny (Blimark CH et al., Clin Lymphoma Myeloma Leuk 2019) z let 2008–2018 u 7 608 pacientů, z nichž alespoň jednoroční sledování proběhlo u více než 5 500 osob. Ukázala, že medián přežití pacientů s mnohočetným myelomem mladších 65 let (většinou po ASCT), kteří dosáhnou dobré odpovědi po 1. linii léčby (míněna VGPR – velmi dobrá parciální remise či lepší), je v současnosti delší než 10 let. Podle registru také významně stoupá počet jedinců transplantovaných ve věku 66–70 let; v tomto věku je ve Švédsku transplantováno až 40 % pacientů s mnohočetným myelomem. Procento švédských pacientů, kteří zrelabovali do jednoho roku od diagnózy, kleslo ze 62 % v roce 2009 na pouhých 26 % v roce 2017, což vysvětluje i zlepšení přežití v 1, 3, 5 až 7 letech. „Zdá se, že mladší, intenzivně léčení nemocní, kteří dosáhnou dobré odpovědi na léčbu, mají dnes šanci žít s myelomem více než 10 let, což je ohromný posun. Bylo to prokázáno na velké skupině sledovaných, ostatně i předběžná data z našeho registru na takto významné prodloužení mediánu přežití ukazují a bude to ještě podrobně analyzováno,“ uvádí prof. MUDr. Ivan Špička, CSc., vedoucí myelomové skupiny I. interní kliniky 1. LF UK a VFN v Praze a člen výboru České myelomové skupiny (CMG).
Na IMW bylo představeno i závěrečné hodnocení studie ELOQUENT-2 s protilátkou elotuzumabem v kombinaci s lenalidomidem a dexametazonem, na které se podíleli i čeští spoluautoři (Dimopoulos MA et al., Clin Lymphoma Myeloma Leuk 2019). Studie byla zaměřena na celkové přežití a potvrdila závěry předchozích analýz ve smyslu statisticky významného prodloužení doby do progrese, celkového přežití (s mediánem 48 oproti 39 měsícům) a 18% snížení rizika úmrtí po přidání elotuzumabu ke kombinaci RD. Tato léková kombinace se jeví jako bezpečná a výsledky byly nezávislé na všech potenciálních rizikových faktorech (pokročilé stadium choroby, ISS 3, negativní cytogenetika, vyšší předléčenost ve smyslu 2–3 linií léčby). „Také do této studie bylo v ČR zařazeno hodně pacientů s dobrými výsledky. Výjimkou nejsou jedinci, kteří dostávají elotuzumab sedm a více let a zůstávají nadále v kompletní remisi. Jedná se o bezpečnou a dlouhodobě účinnou terapii mnohočetného myelomu, která je u nás však schválena s nemalými indikačními omezeními,“ uzavírá I. Špička.
(red)
Reklamní sdělení

Reportáže a rozhovory z odborných kongresů
Opouštíte prostředí společnosti Pfizer, spol. s r. o.
Společnost Pfizer, spol. s r. o., neručí za obsah stránek, které hodláte navštívit.
Přejete si pokračovat?